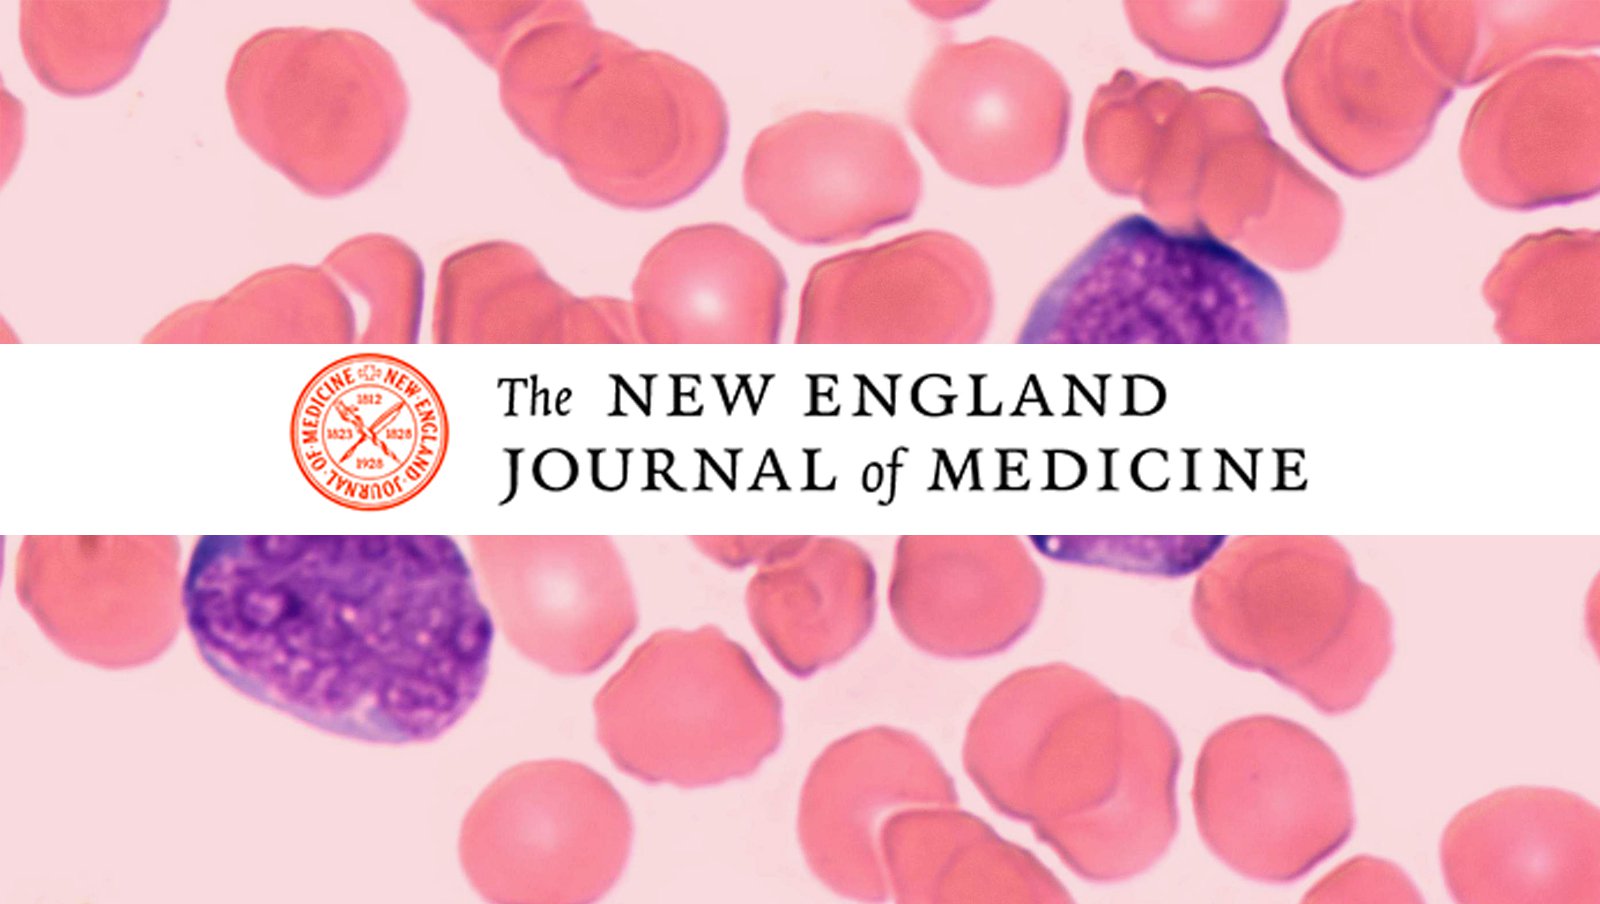
Terapia CAR-T u dorosłych chorych z nawracającym lub opornym na leczenie chłoniakiem rozlanym z dużych komórek B

Rokowanie u chorych na chłoniaka rozlanego z dużych komórek B (DLBCL, diffuse large B-cell lymphoma) opornego na leczenie pierwszej i drugiej linii lub nawracającego po przeszczepieniu komórek macierzystych jest niekorzystne. Działanie tisagenlecleucelu, czyli terapii komórkowej zawierającej limfocyty T wykazujące ekspresję chimerycznego receptora antygenowego (CAR, chimeric antygen receptor), polega na eliminacji limfocytów B z ekspresją CD19. Skuteczność tej terapii u chorych na chłoniaki B-komórkowe wykazano w jednoośrodkowym badaniu klinicznym fazy 2a.
Materiał przeznaczony wyłącznie dla pracowników służby zdrowia
Ten materiał jest dostępny dla zarejestrowanych użytkowników.
Zaloguj się
Szanowni użytkownicy,
część materiałów udostępnianych na naszym portalu jest przeznaczona
wyłącznie dla lekarzy.
Wynika to z regulacji prawnych, do których musimy się stosować.
Jeśli nie jesteś lekarzem, zachęcamy do korzystania z przygotowanych przez nas materiałów dostępnych w zakładce dla pacjentów.











